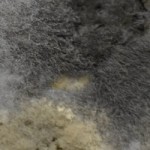
Mold

Edited by Jennifer Willet, this issue address issues of bio-mobility from a variety of perspectives. With contributions from artists, theorists, programmers and tinkerers, this issue serves to address bio-mobility in relation to biomedia, bioart, biotechnology, biomedicine, ecology, phenomenology, embodiment, performance, and even re-animation of biomaterials.